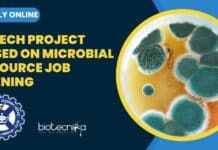
IMTECH Project Based On Microbial Resource Job Opening, Apply Online IMTECH Microbiology Project Research
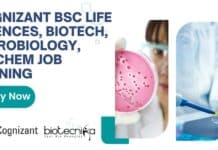
Cognizant BSc Life Sciences, Biotech, Microbiology, Biochem Job Opening, Apply Now Cognizant BSc Life Sciences

IMTECH Project Based On Microbial Resource Job Opening, Apply Online
IMTECH Microbiology Project Research Job Opening, Apply Online
IMTECH Microbiology Project Research Job Opening, Apply Online. MSc Natural and Agricultural Sciences Project job. Project Associate...
How to Choose Career Path? Less Competition, More Scope & More Successful
Career Planning: How to Decide Which Field Will Have Less Competition, More Scope & Better Chances of Success
Are you a student, a recent graduate,...
ILS Recruitment 2023 For MSc Life Sciences, Biotech, Biochem, Microbiology JRF Job
ILS Recruitment 2023 For MSc Life Sciences, Biotech, Biochem, Microbiology JRF Job
ILS Recruitment 2023 For MSc Life Sciences, Biotech, Biochem, Microbiology JRF Job. MSc...
ILS Bhubaneswar SRF Job For MSc Biotech, Biochem, Microbiology, Life Sciences – Apply Online
Government Jobs in Bhubaneswar - MSc Life Sciences, Biotech, Biochem, Microbiology SRF Job at ILS
Government Jobs in Bhubaneswar - MSc Life Sciences, Biotech, Biochem,...
National Institute of Immunology Field Assistant Job For BSc Life Sciences Candidates
Delhi-NCR Region Jobs For BSc Life Sciences Sciences Candidates at NII
Delhi-NCR Region Jobs For BSc Life Sciences Sciences Candidates at NII. BSc Life Sciences...
Zero Meat Internship – Food Science & Food Tech Candidates Apply For Product Development...
Food Technology Internship For Food Tech & Food Science Candidates at Zero Meat
Food Technology Internship For Food Tech & Food Science Candidates at Zero...
Avantor Job For Biotech, Biochem, Microbiology : 0-6 Months Experience Required | Apply Online
Avantor Biotech Freshers Job. Avantor Associate Job, Biotechnology, Biochemistry, Microbiology Apply Online. Graduate Life Sciences Jobs. Interested and eligible candidates can check out the...
Biocon Academy Webinar On Biotechnology Careers: Opportunities and Paths to Success Hosted By Biotecnika
Biocon Academy Webinar 2023 On Biotechnology Careers: Opportunities and Paths to Success Hosted By Biotecnika
Biocon Academy & Biotecnika presents
Industry-sponsored webinar
Biotechnology Careers: Opportunities and Paths...
Shiv Nadar PhD Life Sciences/ Bioinformatics Admissions 2023 – Apply Now
Shiv Nadar PhD Admissions 2023 For PhD Life Sciences/ Bioinformatics
Shiv Nadar PhD Admissions 2023 For PhD Life Sciences/ Bioinformatics. Ph.D. Admissions Announcement: Monsoon 2023....
Biotecnika Times Newsletter 13.04.2023 Internships, Cipla Hiring, IQVIA Jobs, Cognizant + Much More
Research & Development Intern at Jana Care For BSc Biotech & Life Sciences
Research & Development Intern at Jana Care For BSc Biotech & Life...
CFTRI MSc, BTech & MTech Food Science Technology Project Jobs, Apply Online
CFTRI Project Openings 2023 For MSc, BTech & MTech Food Science Technology
CFTRI Project Opening 2023 For MSc, BTech & MTech Food Science Technology, Apply...
ICMR-NIRRCH Non-Med Scientist Job For MSc & PhD Candidates, Apply Online
ICMR-NIRRCH Non-Med Scientist Job For MSc & PhD Candidates, Apply Online
ICMR-NIRRCH Non-Med Scientist Job For MSc & PhD Candidates, Apply Online. NIRRH recruitment for...
NARI Tech Officer Job For BSc, MSc & PhD Candidates From Life Sciences
NARI Tech Officer Job For BSc, MSc & PhD Candidates From Life Sciences
NARI Tech Officer Job For BSc, MSc & PhD Candidates From Life...
Labcorp MSc Biotech, Biochem, Zoology & Microbiology Job Opportunity, Apply Online
Labcorp MSc Biotech, Biochem, Zoology & Microbiology Job Opportunity, Apply Online
Labcorp MSc Biotech, Biochem, Zoology & Microbiology Job Opportunity, Apply Online. Biotech, Biochem, Zoology...
Cognizant BSc Life Sciences, Biotech, Microbiology, Biochem Job Opening, Apply Now
Cognizant BSc Life Sciences, Biotech, Microbiology, Biochem Job Opening, Apply Now
Cognizant BSc Life Sciences, Biotech, Microbiology, Biochem Job Opening, Apply Now. Life Sciences (Biotech,...